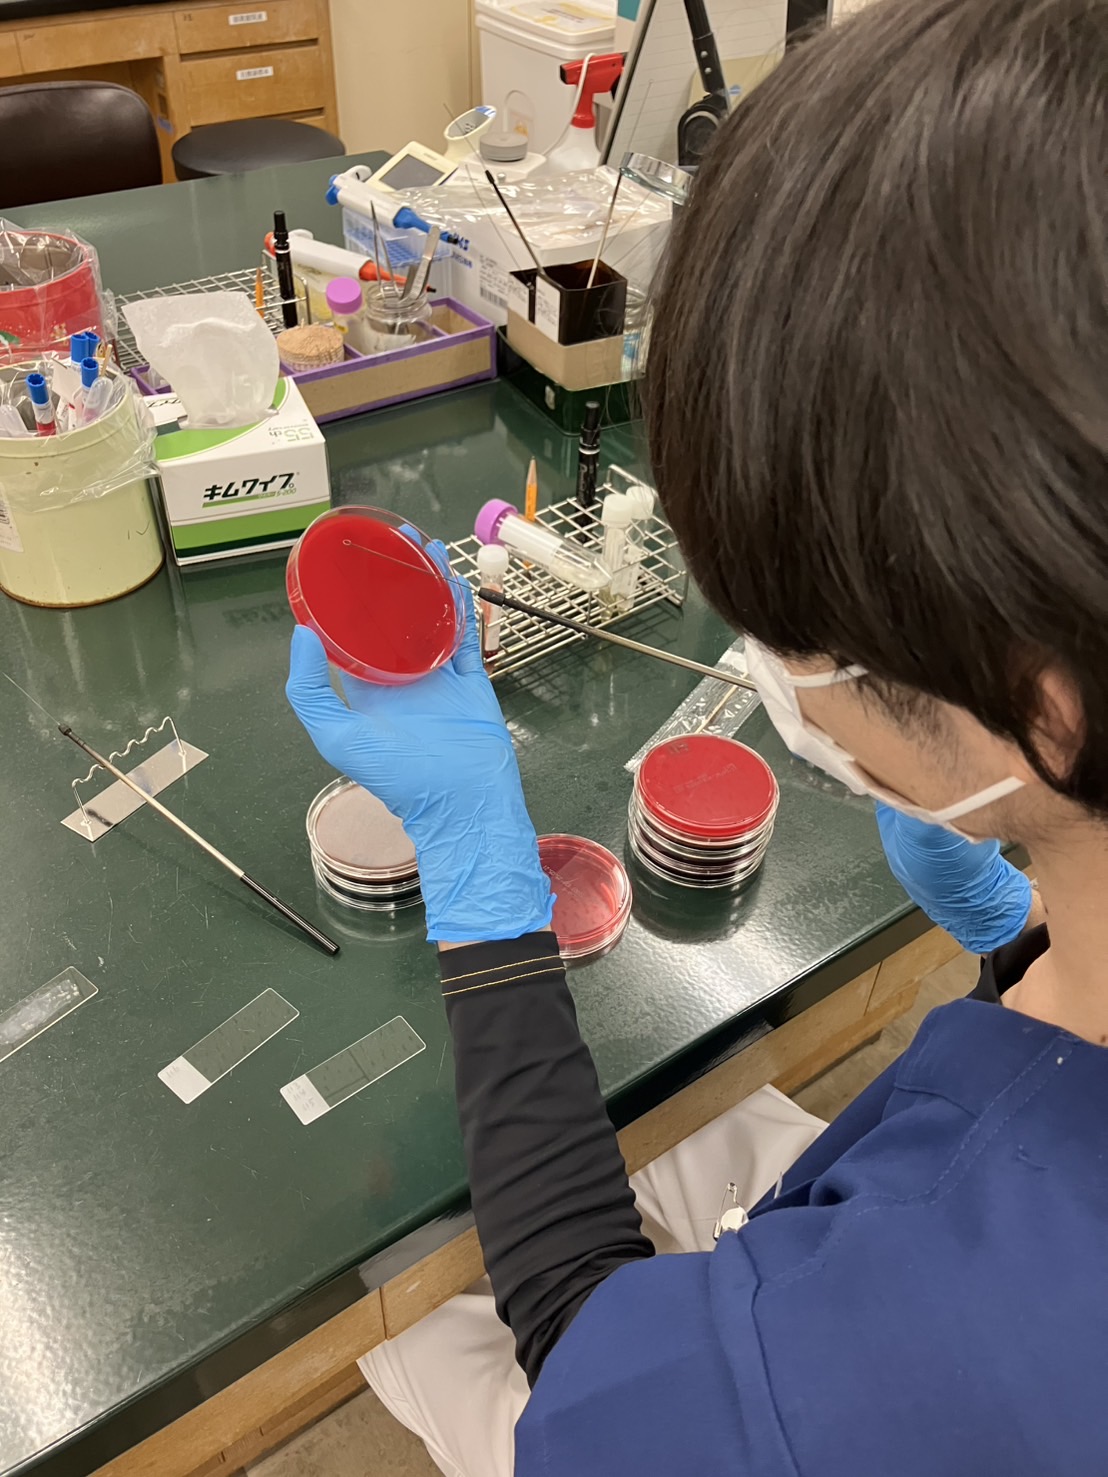
②細菌検査

更新日 2025.04.10
中央検査部
理念
目標
- 正確で精密な検査結果を迅速に診療に提供する。
- 高度な技術や高度な知識の習得に努める。
- チーム医療の一員として他職種との連携に努める。
- 患者様の満足度向上に務める。
あいさつ
中央検査部では、臨床検査の専門的な知識や技術を習得した臨床検査技師が、血液や尿、便、喀痰などの成分を検査する検体検査及び心電図や脳波、超音波などの生理機能検査を行っています。
患者様から採取された血液、尿、便、喀痰などの検査は、24時間365日、ほとんどの検査を1時間以内に診療側へ報告しています。医師は、その結果をもとに診断、治療方針の決定、治療効果の確認などを行います。また、細菌検査・細胞診検査については、奄美群島の中で当検査部のみが院内で検査を実施しています。診療側へ付加価値のある結果報告を心掛け、診断・治療に役立つよう努力しています。
これからも、中央検査部では正確な検査結果の提供と迅速化に努め、患者様への更なる医療サービスの向上を目指します。
臨床検査技師長 狩元 伸一
職員数
臨床検査技師 13名
会計年度任用職員 3名
認定技師
細胞検査士 2名
超音波検査士 2名
認定輸血検査技師 1名
検査紹介(検体検査)
一般検査
 試験紙法を用いた尿分析装置により尿定性9項目(糖・タンパク・ビリルビン・pH・潜血・ウロビリノーゲン・ケトン体・細菌・白血球)と比重を検査しています。尿沈渣(にょうちんさ)と呼ばれる尿中の有形成分の顕微鏡による形態検査も行っています。
試験紙法を用いた尿分析装置により尿定性9項目(糖・タンパク・ビリルビン・pH・潜血・ウロビリノーゲン・ケトン体・細菌・白血球)と比重を検査しています。尿沈渣(にょうちんさ)と呼ばれる尿中の有形成分の顕微鏡による形態検査も行っています。
その他、便潜血検査、体腔液検査等を行っています。
血液検査
 血液中の血球成分(赤血球数、白血球数、血小板数)を検査しています。
血液中の血球成分(赤血球数、白血球数、血小板数)を検査しています。
感染症や貧血、出血傾向を知るための指標となります。
また、凝固系検査(血液を固める機能)も行っています。
輸血検査
 患者様に使用する輸血用血液が適合するか検査しています。
患者様に使用する輸血用血液が適合するか検査しています。
血液型も再度確認します。
輸血に関する検査(血液型、不規則リスクリーニング交差適合試験等)も実施しています。
生化学検査
 肝機能、脂質、腎機能など36項目のほか、炎症反応(CRP)や糖尿病関連の検査を行っています。
肝機能、脂質、腎機能など36項目のほか、炎症反応(CRP)や糖尿病関連の検査を行っています。
免疫学的検査
 感染症(B型、C型肝炎・梅毒・HTLV-1他)、腫瘍マーカー(CEA・AFP・CA19-9・PSA他)、甲状腺機能検査(TSH,FT3,FT4)、血中薬物濃度(フェニトイン・バンコマイシン・バルプロ酸・カルマバゼピン)などの検査を行っています。
感染症(B型、C型肝炎・梅毒・HTLV-1他)、腫瘍マーカー(CEA・AFP・CA19-9・PSA他)、甲状腺機能検査(TSH,FT3,FT4)、血中薬物濃度(フェニトイン・バンコマイシン・バルプロ酸・カルマバゼピン)などの検査を行っています。
細菌検査
敗血症、肺炎、胃腸炎などの患者様から採取した検査材料から原因菌を検出し、どの薬が治療に有効か調べます。
敗血症、肺炎、胃腸炎などの患者様から採取した検査材料から原因菌を検出し、どの薬が治療に有効か調べます。
細胞診検査
 喀痰や尿、分泌物、針で採取した細胞などの中に、ガン細胞があるかどうかを顕微鏡で調べます。
喀痰や尿、分泌物、針で採取した細胞などの中に、ガン細胞があるかどうかを顕微鏡で調べます。
病理検査
 手術や内視鏡検査などにより採取された臓器の一部を顕微鏡で観察して診断を行います。
手術や内視鏡検査などにより採取された臓器の一部を顕微鏡で観察して診断を行います。
術中迅速病理診断や病理解剖などにも対応しています。
検査紹介(生理機能検査)
生理機能検査
 心電図・肺機能・脳波・ABI(血圧脈波検査)・APG(負荷前後容積脈波)・ホルター心電図・睡眠時無呼吸症候群検査・神経伝導速度・超音波(頚部・腹部・下肢静脈)検査などを行っています。
心電図・肺機能・脳波・ABI(血圧脈波検査)・APG(負荷前後容積脈波)・ホルター心電図・睡眠時無呼吸症候群検査・神経伝導速度・超音波(頚部・腹部・下肢静脈)検査などを行っています。











